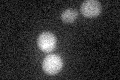
YBR230C
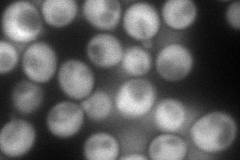
YBR230C
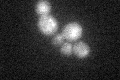
YBR230C

View description
Integral mitochondrial outer membrane protein; abundance is decreased in cells grown in glucose relative to other carbon sources; appears to contain 3 alpha-helical transmembrane segments; ORF encodes a 97-basepair intron
Localization:
Intensity:
Fold change:
Significance:
-
C’ GFP library in SD
below threshold18.05 -
N' NOP1pr-GFP in SD
cytosol143.927 -
N' TEF2pr-mCherry in SD

mitochondria288.431 -
N' NATIVEpr-GFP in SD

cytosol62.7327 -
N' TEF2pr-VC and Cyto-VN in SD

mitochondria76.8659 -
C’ GFP library in SD+DTT
cytosol14.630.81No -
C’ GFP library in SD+H2O2

cytosol16.580.91No -
C’ GFP library in Starvation Media

cytosol17.090.94No -
C’ GFP library on the background of Pup2-DaMP

N/A -
C’ GFP library on the background of CCT mutant

N/A0N/AYes
